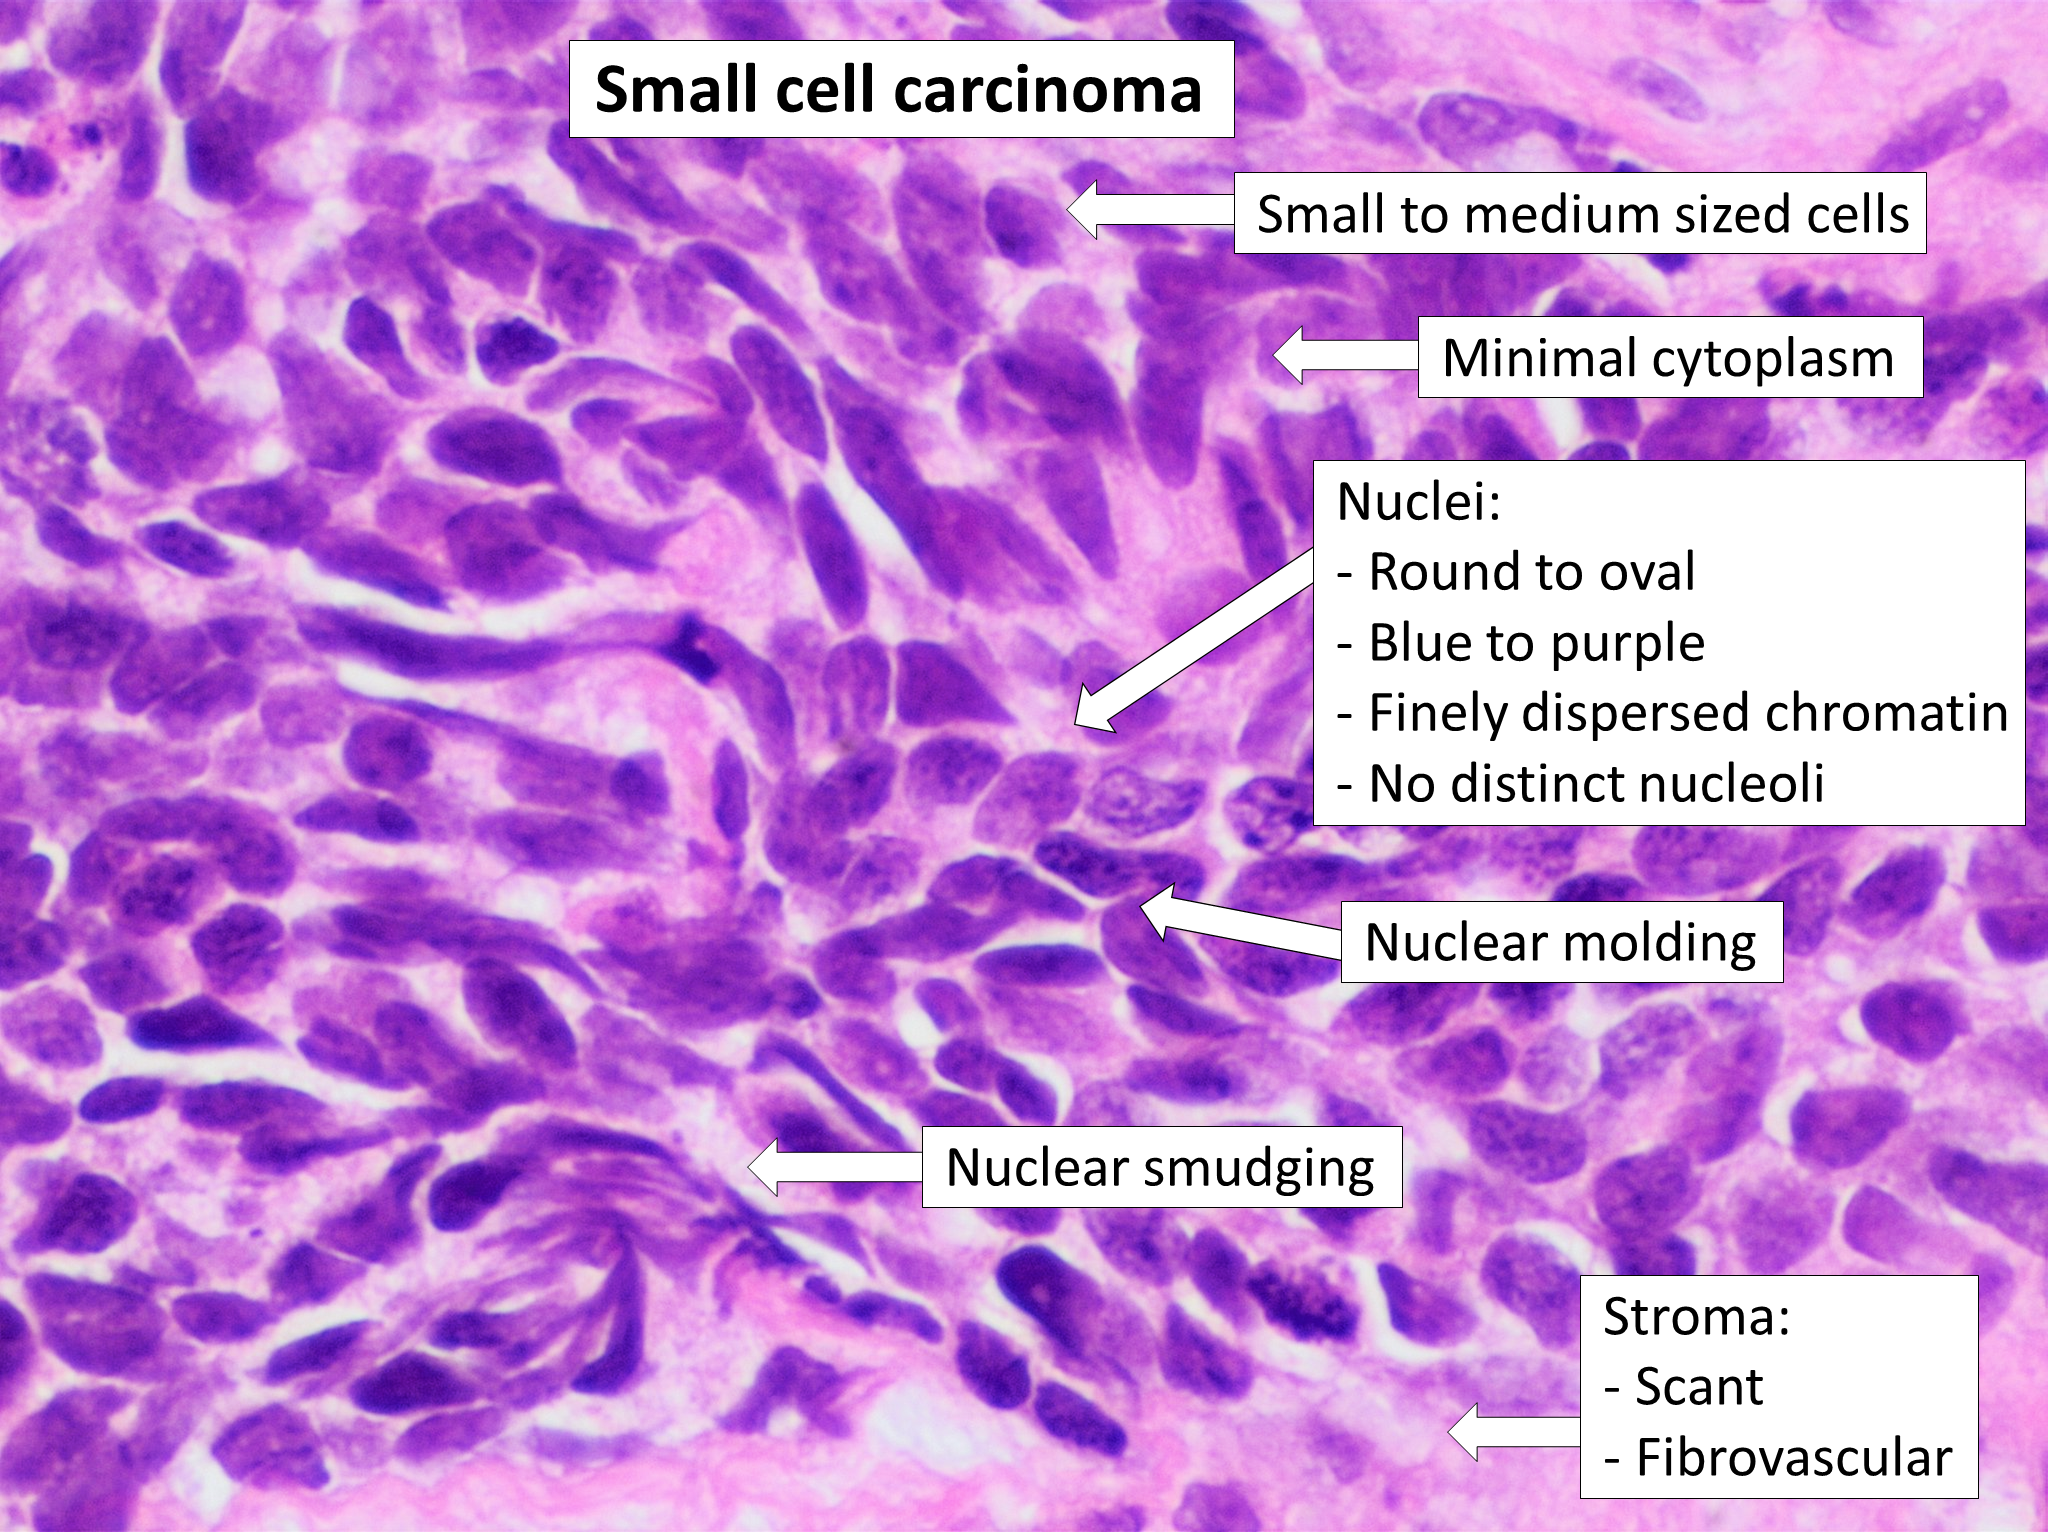

소세포암종
"오늘의AI위키"의 AI를 통해 더욱 풍부하고 폭넓은 지식 경험을 누리세요.
1. 개요
소세포암종은 주로 폐에서 발생하는 악성 종양으로, 폐암의 한 종류이다. 소세포암종은 폐암 중에서도 예후가 좋지 않으며, 림프절 침투와 원격 전이가 빠르게 진행된다. 종류로는 소세포 폐암, 혼합 소세포 폐암, 폐외 소세포암 등이 있다. 흡연은 주요 위험 요인이며, 흉부 X선, CT, 조직 검사 등을 통해 진단한다. 치료는 화학 요법, 방사선 치료, 면역 치료 등이 사용되며, 재발 시에는 다른 치료법을 시도한다. 5년 생존율은 낮지만, 최근 면역 치료 등의 발전으로 치료 성과가 개선되고 있다.
더 읽어볼만한 페이지
- 세포병리학 - 림프절병증
림프절병증은 림프절 비대 상태를 의미하며, 발생 위치, 범위, 원인에 따라 다양하게 분류되고, 진단은 신체 검사, 영상 검사, 조직 검사 등을 통해 이루어진다. - 폐암 - 폐선암
폐선암은 폐의 선 세포에서 발생하는 악성 종양으로, 흡연이 주요 위험 요인이며, 다양한 영상 검사와 조직 검사를 통해 진단하고 병기에 따라 수술, 항암 치료 등 다양한 방법으로 치료한다. - 폐암 - 폐의 기저세포양 편평세포암
폐의 기저세포양 편평세포암은 편평 세포 폐암의 변종으로, 기도 이형성증과 관련이 있으며, 면역조직화학 염색을 통해 진단되고, 표준 프로토콜에 따라 치료되지만 예후가 좋지 않으며 흡연과 관련이 깊다. - 암종 - 기저세포암
기저세포암은 햇빛 노출 부위에 주로 발생하는 가장 흔한 피부암으로, 윤기 있는 결절이나 붉은 반점 형태로 나타나며, 기저 세포 증식으로 발생하지만 전이가 드물고 다양한 치료법이 존재한다. - 암종 - 이행세포암종
이행세포암종은 이행상피세포에서 기원하는 악성 종양으로, 흡연, 특정 화학 물질, 방사선 노출 등이 위험 요인이며, 혈뇨를 유발하고, 외과적 절제술, 화학 요법, 면역 요법 등으로 치료하며, 유전체 이상이 발병에 관여한다.
2. 종류
소세포암은 발생하는 위치와 형태에 따라 다음과 같이 분류된다.
- 소세포 폐암 (Small-cell lung cancer, SCLC): 폐에서 발생하는 소세포암으로, "귀리 세포 암종"이라고도 불린다. 제한적 병기와 광범위 병기로 나뉜다.
- 혼합 소세포 폐암 (Combined small-cell lung carcinoma, c-SCLC): 소세포 폐암이 다른 형태의 폐암과 함께 발견되는 경우이다.
- 폐외 소세포암 (Extrapulmonary small-cell carcinoma, EPSCC): 폐 외부에서 발생하는 소세포암으로, 자궁경부, 전립선, 간, 췌장, 위장관, 방광 등에서 나타날 수 있다.[16] 피부가 원발 부위인 경우 머켈 세포 암종이라고 한다.[18]
- 림프절 국한 폐외 소세포암종: 림프절에서만 발생하는 매우 드문 형태이다.
- 전립선 소세포암 (Small-cell carcinoma of the prostate): 전립선암의 약 1%를 차지하는 드문 형태이다.[20]
2. 1. 소세포 폐암 (Small-cell lung cancer)
소세포 폐암(Small-cell lung cancer, SCLC)은 폐에서 발생하는 소세포암종으로, 대부분의 소세포암이 여기에 해당한다. 때때로 납작한 세포 모양과 빈약한 세포질 때문에 "귀리 세포 암종"이라고 불리기도 한다.[10]기관지의 신경내분비 세포(페이터 세포)에서 유래한다고 알려져 있다. 이 때문에 소세포암은 신경내분비 표지를 생성하고, 항이뇨호르몬이나 부신피질자극호르몬과 같은 이소성 호르몬 생성을 유도하여 방종양성 증후군이나 쿠싱 증후군을 일으킬 수 있다. 램버트-이튼 증후군(LEMS)으로 진단된 환자의 절반 이상이 소세포암으로 밝혀지기도 한다.
소세포암은 비소세포 폐암보다 훨씬 빠르고 광범위하게 전이되는 경향이 있으며,[93] 보통 폐문과 종격 림프절의 초기 침투가 동반된다.[94] 전이 과정은 아직 명확하게 밝혀지지 않았다.[31]
편평 세포 암종이나 선암종과 같이 한 개 이상의 개별화된 폐암 형태가 발견되면, 혼합 소세포 폐암종 (c-SCLC)으로 분류된다. C-SCLC는 현재 소세포암종의 아형으로 분류된다.
소세포 폐암은 제한적 병기 (LS)와 광범위 병기(ES)의 두 가지 임상 병리학적 병기로 구분된다.[8] 종양이 한쪽 폐에만 있고 림프절이 그 폐에 가깝다면 제한기, 그 이상을 넘는다면 확장기라고 부른다.[88]
2. 1. 1. 제한기-소세포암 (Limited-stage small-cell lung carcinoma)
소세포암은 제한적 병기(LS)와 광범위 병기(ES)의 두 가지 임상 병리학적 병기로 구분된다.[8] 제한기에는 시스플라틴이나 카보플라틴, 에토포시드를 병용하는 화학 요법과 흉부 방사선치료를 함께 사용한다.[89][90][91] 흉부 방사선 치료는 제한기 소세포암 환자의 생존율을 높여주는 것으로 나타났다.[35][54]2. 1. 2. 확장기-소세포암 (Extensive-stage small-cell lung carcinoma)
확장기(ES) 소세포암종에서 백금 기반 병용 화학 요법이 표준 치료법이다.[38]병용 화학 요법은 시스플라틴, 사이클로포스파미드, 빈크리스틴, 카보플라틴 등의 약제로 구성된다. 진행성 질환에서도 반응률은 높으며, 15~30%의 환자가 병용 화학 요법에 완전 반응을 보이고, 대다수는 최소한의 객관적인 반응을 보인다. 그러나 ES-SCLC의 반응은 종종 짧은 기간 동안만 지속되며, 진행성 SCLC 환자에게 화학 요법의 잠재적 이점과 치료 위험을 비교한 증거는 명확하지 않다.[38]
2. 2. 혼합 소세포 폐암 (Combined small-cell lung carcinoma)
소세포 폐암(SCLC)이 편평 세포 암종 또는 선암종과 같은 하나 이상의 분화된 형태의 폐암과 함께 발견되면, 악성 종양은 혼합 소세포 폐암종(c-SCLC)으로 진단 및 분류된다.[13][14][15] 혼합 소세포 폐암종은 소세포 폐암이 매우 복잡한 악성 조직 혼합을 포함하여 다양한 다른 폐암 조직학적 변종과 함께 발생할 수 있다. C-SCLC는 현재 인식되는 SCLC의 유일한 아형이다.2. 3. 폐외 소세포암 (Extrapulmonary small-cell carcinoma)
폐외 소세포암(EPSCC)은 소세포암종이 폐와 흉강 외부에서 발생하는 드문 경우이다. 호흡기 외 소세포암종은 자궁경부, 전립선, 간, 췌장, 위장관 또는 방광에서 나타날 수 있다.[16] 미국에서는 연간 1,000건의 새로운 사례가 발생하는 것으로 추정된다.[17]조직학적으로 소세포 폐암과 유사하며, 치료법도 유사하다.[17] 1차 치료는 시스플라틴과 에토포시드를 함께 사용하며, 일본에서는 이리노테칸과 시스플라틴을 함께 사용하는 방식으로 바뀌고 있다. 원발 부위가 피부인 경우는 머켈 세포 암종이라고 한다.[18]
전립선암 중 전립선 소세포암은 매우 드물게 발생하며(약 1%), 전립선 특이 항원 수치의 변화가 거의 없어 전이 후 말기에 발견되는 경우가 많다. 뇌전이는 드물지만 예후가 나쁘다.
2. 3. 1. 림프절에 제한된 폐외 소세포암종 (Extrapulmonary small-cell carcinoma localized in the lymph nodes)
매우 드문 소세포암종의 형태로, 학계에 알려진 정보가 거의 없다. 하나 이상의 림프절에서만 발생하며, 신체의 다른 부위에서는 발생하지 않는 것으로 보인다. 치료는 소세포 폐암과 유사하지만, 생존율은 다른 소세포암종보다 훨씬 높다.[19]2. 4. 전립선 소세포암 (Small-cell carcinoma of the prostate)
전립선 소세포암은 전립선암 중에서도 매우 희귀하다.(대략 1%[20]) 전립선 특이 항원 수치의 변화가 거의 없기 때문에 전립선 소세포암은 전이 후의 말기에서 발견된다. 전립선 소세포암의 뇌전이는 매우 드물고, 나쁜 예후를 보인다.[21]3. 증상
소세포암은 초기에는 증상이 없는 경우가 많다. 하지만, 암이 진행되면서 다음과 같은 증상들이 나타날 수 있다.
- 기침: 가장 흔한 증상 중 하나이다.
- 호흡 곤란: 숨쉬기가 어려워지는 증상이다.
- 체중 감소: 특별한 이유 없이 체중이 줄어든다.
- 쇠약: 몸에 힘이 없고 피곤함을 느낀다.
소세포암은 간, 부신, 뼈, 뇌 등 다른 장기로 전이되는 경우가 많다.[92] 또한, 부신피질자극호르몬(ACTH)이나 항이뇨호르몬(ADH)과 같은 이소성 호르몬을 만들어 내기도 한다.[92] 이러한 호르몬 때문에 여러 가지 문제가 발생할 수 있는데, 예를 들어 항이뇨호르몬 분비이상 증후군(SIADH)이 나타날 수 있다.[92]
램버트-이튼 근무력증 증후군(LEMS)과 같이 암 때문에 생기는 특이한 증상(방종양성 증후군)이 나타나기도 한다.[92] 램버트-이튼 근무력증 증후군으로 진단받은 사람들의 절반 정도는 결국 소세포암을 가지고 있는 것으로 밝혀진다.
4. 원인 및 유전학
소세포암종은 기관지의 신경내분비 세포 (APUD 세포, 페이터 세포)에서 유래한다고 알려져 있다.[93] 이 세포의 특성 때문에, 소세포암종은 신경내분비 표지를 생성하고, 항이뇨호르몬이나 부신피질자극호르몬과 같은 이소성 호르몬을 만들어 부종양 증후군이나 쿠싱 증후군을 유발하기도 한다.
소세포암종은 비소세포폐암보다 훨씬 빠르고 넓게 전이되는 특징을 보인다.[93] 주로 폐문과 종격 림프절에 초기에 침투하는 경우가 많다.[94]
TP53 유전자는 소세포암종의 70~90%에서 변이가 발견된다.[26] RB1 유전자와 망막모세포종 경로는 대부분 비활성화되어 있다. PTEN 유전자는 2~10%에서 변이가 나타나며, MYC 유전자 및 MYC 계열 구성원의 증폭은 소세포암종의 30%에서 발견된다.[26] 3p 염색체 팔의 이형 접합성 소실은 FHIT의 소실을 포함하여 80% 이상에서 발견된다.[26] 현재까지 100건의 염색체 전좌가 보고되었다.[27][28]
5. 진단
소세포암종은 미분화된 신생물로, 원시적인 세포로 구성된다. 이름에서 알 수 있듯이 소세포암종의 세포는 정상 세포보다 작으며, 세포질을 위한 공간이 거의 없다. 일부 연구자들은 이를 세포 크기를 제어하는 메커니즘의 실패로 간주한다.
진단 당시 환자의 60~70%는 이미 전이를 보인다.
6. 치료
소세포암은 항암 화학 요법 및 방사선 치료에 비교적 잘 반응하는 편이다.[89][90][91]
제한기 소세포암의 경우, 병용 화학 요법(주로 시스플라틴이나 카보플라틴, 에토포시드 사용)과 함께 흉부 방사선 치료를 병행한다.[32][33][34] 흉부 방사선 치료는 제한기 소세포암 환자의 생존율을 높이는 것으로 나타났다.[35]
확장기 소세포암에서는 백금 기반 화학 요법이 표준 치료법이다.[38] 병용 화학 요법은 시스플라틴, 사이클로포스파미드, 빈크리스틴, 카보플라틴 등 다양한 약제로 구성된다. 진행성 질환에서도 반응률이 높아, 15~30%의 환자가 완전 반응을 보이며, 대다수는 최소한의 객관적인 반응을 보인다. 그러나 확장기 소세포암의 반응은 종종 짧게 지속되며, 화학 요법의 잠재적 이점과 치료 위험에 대한 근거는 명확하지 않다.[38]
드물게 소세포암이 폐 외부(폐외 소세포암, EPSCC)나 흉막에 발생하는 경우가 있다. 폐외 소세포암은 전립선, 간, 췌장, 위장관, 방광 등에서 나타날 수 있으며, 미국에서는 연간 1,000건 정도 보고된다. 조직학적으로 소세포암과 유사하여, 소세포암 치료법이 EPSCC 치료에 사용된다.[16][17] 1차 치료는 주로 시스플라틴과 에토포사이드를 사용하며, 일본에서는 이리노테칸과 시스플라틴을 사용하기도 한다.[18]
6. 1. 화학 요법
소세포암은 한 가지 약물보다는 두 가지 약물을 함께 사용하는 것이 훨씬 효과적이다.# 시스플라틴과 에토포사이드
# 카보플라틴과 에토포사이드
파클리탁셀은 시스플라틴 내성 암에 유용한 치료제이다. 파클리탁셀 저항세포의 66.7%, 시스플라틴 내성암의 68.1%는 파클리탁셀에 민감한 것으로 보인다. 이 활동의 메커니즘은 알려져 있지 않다.[39] 새로운 약물인 루르비넥테딘은 재발성 소세포폐암에 효과가 있으며, 2020년 6월 미국에서 의료용으로 승인되었다.[41][42][43][44][45]
테모졸로마이드와 벤다무스틴을 포함한 몇몇 새로운 제제들이 재발한 소세포암에서 활동성을 갖는다. 특히 테모졸로마이드는 소세포암으로 인해 뇌전이에서 38%의 반응률을 보인다.[57]
50명의 환자들을 대상으로 한 임상 시험에서, 재발성 소세포 폐암에 올라파립과 테모졸로마이드의 병용 투여 시 전체 반응률 41.7%, 무진행 생존 기간 중앙값 4.2개월, 전체 생존 기간 8.5개월을 나타냈다.[58]
루르비넥테딘은 임상 시험에서 재발성 소세포 폐암 환자의 전체 생존율을 증가시켰다.[59]
CKD 억제제인 트릴라시클립은 소세포 폐암 치료를 받는 환자에서 화학요법으로 인한 독성을 감소시킨다.[63][64][65]
2021년, FDA는 진행성 소세포 폐암 환자에게 특정 유형의 화학 요법을 투여받는 환자들의 화학 요법으로 유발된 골수 억제 빈도를 줄이기 위한 치료제로 트릴라시클립(Cosela)을 승인했다.[66]
6. 2. 면역 치료
2018년, 미국 식품의약국(FDA)은 소세포폐암에 대해 세 가지 면역 치료법을 승인했다.[46][47]- 니볼루맙(옵디보, Opdivo), PD-1 억제제[48][49]
- 아테졸리주맙(테센트릭, Tecentriq), PD-L1 억제제[50][51]
- 타르라타맙, 이중 특이 T 세포 인게이저[52][53]
캐나다 규제 기관은 2020년에 광범위 병기 소세포폐암에 대한 테센트릭(아테졸리주맙)의 자금 지원을 "과도한 비용"을 이유로 거부했으며, 영국 또한 "약물의 비용 효과성"을 언급하며 거부했다.
6. 3. 방사선 치료
흉부 방사선 치료는 소세포암종 환자의 생존율을 높이는 데 도움이 된다.[89][90][91][35] 가슴 방사선 치료는 암세포를 죽이고 암 재발을 예방하여 소세포 폐암 환자의 생존 기간을 연장하는 데 기여한다.[54]예방적 뇌 방사선 치료는 뇌 전이를 예방하며, 국한 병기(LD)에서 화학 방사선 요법을 받거나 확장 병기(ED)에서 화학 요법을 받은 후 완전 관해 또는 매우 훌륭한 부분 관해를 보이고, 전신 상태가 양호한 환자의 생존율을 향상시킬 수 있다.[1]
6. 4. 재발 시 치료
소세포암 재발 시, 다음 약물 조합을 구제 요법으로 사용할 수 있다.[55]파클리탁셀 단독 요법이나 이리노테칸도 사용할 수 있다.[56][57]
초기 치료 6개월 후 재발한 환자는 기존 화학 요법을 다시 받을 수 있다. 6개월 이내 재발 환자는 토포테칸 2차 요법을 고려할 수 있다.[57]
테모졸로마이드, 벤다무스틴 등 새로운 약제도 재발성 소세포암에 효과적이다. 특히 테모졸로마이드는 뇌 전이에서 38% 반응률을 보였다.[57] 올라파립과 테모졸로마이드 병용 투여 시 전체 반응률은 41.7%였다.[58]
루르비넥테딘은 재발성 소세포암 환자 생존율을 높이는 신약으로, 2020년 6월 미국에서 승인되었다.[41][42][43][44][45]
CKD 억제제인 트릴라시클립은 화학요법으로 인한 독성을 감소시킨다.[63][64][65] 2021년, FDA는 골수 억제 감소 치료제로 트릴라시클립(Cosela)을 승인했다.[66]
7. 예후
소세포암은 예후가 좋지 않은 암으로 알려져 있다. 5년 생존율은 제한기(암이 한쪽 폐와 주변 림프절에 국한된 경우)에서 21.3%, 확장기(암이 더 넓게 퍼진 경우)에서 2.8% 정도로 매우 낮다.[68] 여성의 생존율이 남성보다 약간 높은 경향을 보인다.
구체적으로 살펴보면, 모든 성별과 인종에서 5년 생존율은 다음과 같다.
여성의 경우 남성보다 5년 생존율이 더 높게 나타난다.
최근에는 화학 요법에 면역 요법을 추가하는 등 치료법 발전을 통해 생존율을 높이려는 노력이 계속되고 있다.[73] 그러나 여전히 중앙 생존 기간은 약 1년 정도로, 폐암 아형 중 가장 예후가 나쁘다.[73]
소세포암은 화학 요법 및 방사선 요법에 민감하게 반응하며, 특히 백금 기반 치료에 효과적이다.[69] 그러나 대부분의 환자는 재발하며, 장기 생존율은 여전히 낮은 편이다.[69] 1975년부터 2014년까지 5년 상대 생존율은 3.6%에서 6.7%로 증가했지만, 여전히 개선의 여지가 많다.[67]
8. 역학
소세포암은 폐암의 약 15%를 차지한다.[74][75] 주로 흡연자에게서 발생하며, 비흡연자에게서는 드물다.[76][77]
9. 사회
2013년, 미국 의회는 난치성 암 연구법을 통과시켰는데, 이는 소세포 폐암을 포함한 특정 난치성 암(5년 상대 생존율이 50% 미만인 암)에 대한 관심을 높이도록 규정했다. 그 결과, 국립 암 연구소는 소세포암종에 특화된 연구를 지원하게 되었다.[78][79]
참조
[1]
DorlandsDict
small-cell carcinoma
nine/000951105
[2]
논문
Advanced small cell carcinoma of the uterine cervix treated by neoadjuvant chemotherapy with irinotecan and cisplatin followed by radical surgery
2011-03
[3]
논문
Pure small cell carcinoma of the prostate: a case report and literature review
2011-02
[4]
간행물
Small Cell Lung Cancer
http://www.ncbi.nlm.[...]
StatPearls Publishing
2023-10-02
[5]
웹사이트
Small Cell Lung Cancer
https://rarediseases[...]
[6]
웹사이트
Small cell carcinoma of the Lung and Bronchus
https://seer.cancer.[...]
U.S. National Cancer Institute
2016
[7]
웹사이트
Small cell carcinoma of the Lung and Bronchus SEER 5-Year Relative Survival Rates, 2011-2017 By Sex and Race/Ethnicity, Ages 50-64, Distant
https://seer.cancer.[...]
U.S. National Cancer Institute
2016
[8]
논문
Chemotherapy advances in small-cell lung cancer
2013-10
[9]
논문
Staging and clinical prognostic factors for small-cell lung cancer
[10]
웹사이트
Small Cell Mesothelioma
https://www.asbestos[...]
[11]
서적
Robbins and Cotran pathologic basis of disease
Elsevier Saunders
[12]
서적
Robbins Basic Pathology
Saunders
[13]
서적
Pathology and Genetics of Tumours of the Lung, Pleura, Thymus and Heart
http://www.iarc.fr/e[...]
IARC Press
2010-03-27
[14]
논문
Combined small-cell carcinoma of the lung with quadripartite differentiation of epithelial, neuroendocrine, skeletal muscle, and myofibroblastic type
2011-04
[15]
논문
A combined small cell carcinoma of the lung containing three components: small cell, spindle cell and squamous cell carcinoma
2004-11
[16]
논문
A rare bladder cancer--small cell carcinoma: review and update
2011-11
[17]
EMedicine
Extrapulmonary Small Cell Carcinoma
[18]
웹사이트
Merkel-cell carcinima
https://www.dynamed.[...]
2021-08-01
[19]
논문
Extrapulmonary small cell carcinoma localized in lymph nodes: is it a different clinical entity?
[20]
논문
Small-cell carcinoma of the prostate
1997-06
[21]
논문
Brain metastasis from prostate small cell carcinoma: not to be neglected
2002-11
[22]
논문
Specific organ metastases and survival in small cell lung cancer
2012-10
[23]
논문
Mechanisms of small cell lung cancer metastasis
2021-01
[24]
논문
SIADH associated with ciprofloxacin
2013-10
[25]
논문
Lambert-Eaton myasthenic syndrome: tumor versus nontumor forms
[26]
웹사이트
Lung: Translocations in Small Cell Carcinoma
http://atlasgenetics[...]
2018-04-30
[27]
웹사이트
Mitelman Database of Chromosome Aberrations and Gene Fusions in Cancer
http://cgap.nci.nih.[...]
[28]
웹사이트
Atlas of Genetics and Cytogenetics in Oncology and Haematology
http://Atlasgenetics[...]
[29]
웹사이트
Lung - Small cell carcinoma
[30]
논문
Mysteries of the cell. How does a cell know its size?
2011-11
[31]
논문
Investigating Tumor Heterogeneity in Mouse Models
2020-03
[32]
웹사이트
Limited-stage small cell lung cancer: Initial management
https://www.uptodate[...]
UpToDate
2019-06-02
[33]
웹사이트
Small Cell Lung Cancer Treatment
https://www.cancer.g[...]
National Cancer Institute, United States Department of Health and Human Services
2019-06-02
[34]
논문
Limited small-cell lung cancer: a potentially curable disease
https://www.cancerne[...]
2021-08-01
[35]
논문
Consolidative radiation therapy for extensive-stage small cell lung cancer
2015-06
[36]
논문
Clinical biology of small cell carcinoma: relationship to surgical therapy
1978-09
[37]
논문
Surgery for limited stage small cell lung cancer: time to fish or cut bait
2010-02
[38]
논문
Chemotherapy versus best supportive care for extensive small cell lung cancer
2013-11
[39]
논문
A systematic review of platinum and taxane resistance from bench to clinic: an inverse relationship
https://eprints.mdx.[...]
2007-12
[40]
논문
Paclitaxel as third-line chemotherapy for small cell lung cancer failing both etoposide- and camptothecin-based chemotherapy
2017-10
[41]
웹사이트
Zepzelca: FDA-Approved Drugs
https://www.accessda[...]
2020-06-15
[42]
웹사이트
Zepzelca- lurbinectedin injection, powder, lyophilized, for solution
https://dailymed.nlm[...]
2020-06-15
[43]
간행물
Jazz Pharmaceuticals Announces U.S. FDA Accelerated Approval of Zepzelca (lurbinectedin) for the Treatment of Metastatic Small Cell Lung Cancer
https://www.prnewswi[...]
Jazz Pharmaceuticals
2020-06-15
[44]
웹사이트
FDA grants accelerated approval to lurbinectedin for metastatic small
https://www.fda.gov/[...]
2020-06-15
[45]
웹사이트
Drug Trials Snapshots: Zepzelca
https://www.fda.gov/[...]
2020-06-15
[46]
웹사이트
FDA Approves Opdivo for Small Cell Lung Cancer Treatment
https://www.curetoda[...]
2018-08-17
[47]
웹사이트
FDA Approves Opdivo (Nivolumab) for Small Cell Lung Cancer
https://www.cancer.o[...]
[48]
웹사이트
FDA approves atezolizumab for extensive-stage small cell lung cancer
https://www.fda.gov/[...]
[49]
웹사이트
Concurrent Tecentriq Adds First Survival Benefit Seen in Small Cell Lung Cancer in 20 Years
https://www.curetoda[...]
2018-09-25
[50]
웹사이트
FDA grants accelerated approval to tarlatamab-dlle for extensive stage small cell lung cancer
https://www.fda.gov/[...]
2024-05-16
[51]
간행물
FDA approves Imdelltra (tarlatamab-dlle), the first and only T-cell engager therapy for the treatment of extensive-stage small cell lung cancer
https://www.prnewswi[...]
Amgen
2024-05-16
[52]
웹사이트
Canadian regulator considers changes to new drug pricing plan
https://ca.reuters.c[...]
2020-02-20
[53]
웹사이트
NICE Cites Cost in Deciding Against Atezolizumab for Frontline Advanced Small Cell Lung Cancer
https://www.onclive.[...]
2020-01-06
[54]
웹사이트
Study: Chest Radiation Helps Small Cell Lung Cancer Patients Live Longer
https://www.cancer.o[...]
[55]
웹사이트
Treatment for Small Cell Lung Cancer
http://www.cancer.ca[...]
2020-05
[56]
논문
Combination therapy with carboplatin and paclitaxel for small cell lung cancer
2019-01
[57]
논문
Treatment Options for Relapsed Small-Cell Lung Cancer: What Progress Have We Made?
2018-06
[58]
논문
Combination Olaparib and Temozolomide in Relapsed Small-Cell Lung Cancer
2019-10
[59]
논문
Efficacy and safety profile of lurbinectedin in second-line SCLC patients: Results from a phase II single-agent trial.
2019
[60]
간행물
PharmaMar and Bionical Emas Launch Expanded Access Program for Lurbinectedin in Relapsed Small Cell Lung Cancer in the U.S.
https://www.prnewswi[...]
[61]
논문
Antitumor activity of lurbinectedin (PM01183) and doxorubicin in relapsed small-cell lung cancer: results from a phase I study
2017-10
[62]
논문
ATLANTIS: a Phase III study of lurbinectedin/doxorubicin versus topotecan or cyclophosphamide/doxorubicin/vincristine in patients with small-cell lung cancer who have failed one prior platinum-containing line
2019-01
[63]
논문
Myelopreservation with the CDK4/6 inhibitor trilaciclib in patients with small-cell lung cancer receiving first-line chemotherapy: a phase Ib/randomized phase II trial
2019-10
[64]
웹사이트
FDA Grants Priority Review to Trilaciclib to Treat Patients with SCLC
https://www.cancerne[...]
2020-08-17
[65]
웹사이트
Trilaciclib {!} intravenous CDK4/6 inhibitor {!} G1 Therapeutics, Inc.
https://www.g1therap[...]
[66]
웹사이트
FDA Approves Drug to Reduce Bone Marrow Suppression Caused by Chemotherapy
https://www.fda.gov/[...]
2021-02-12
[67]
웹사이트
Table 15.13: Small Cell Cancer of the Lung and Bronchus (Invasive), 5-Year Relative and Period Survival by Race, Sex, Diagnosis Year, Age and Stage at Diagnosis
https://seer.cancer.[...]
Surveillance, Epidemiology, and End Results (SEER), U.S. National Cancer Institute
[68]
웹사이트
Small cell carcinoma of the Lung and Bronchus SEER Relative Survival Rates by Time Since Diagnosis, 2004-2017 By Stage at Diagnosis, Male, All Races (includes Hispanic), All Ages
https://seer.cancer.[...]
U.S. National Cancer Institute
2016
[69]
웹사이트
Small Cell Lung Cancer Treatment
https://www.oncolink[...]
[70]
웹사이트
Exceptional SCLC Survivors: 5-Year Median Survival
https://www.medscape[...]
2016-12-20
[71]
웹사이트
Lung cancer report: "They said it was bronchitis"
https://www.self.com[...]
2009-10-16
[72]
웹사이트
Focus on immunotherapy and patient perspective highlight the IASLC 2019 Small Cell Lung Cancer Meeting
https://www.iaslc.or[...]
2019
[73]
웹사이트
SCLC Prognosis Remains 'Unsatisfactory' Despite Numerous Treatment Options
https://www.cancerne[...]
2023-04-12
[74]
학술논문
Comparison of aspects of smoking among the four histological types of lung cancer
https://www.ncbi.nlm[...]
2008-06
[75]
서적
World Cancer Report 2014
World Health Organization
2014
[76]
학술논문
Changing face of small-cell lung cancer: real and artifact
2006-10
[77]
학술논문
Lung cancer pathology in smokers, ex-smokers and never smokers
1995-01
[78]
웹사이트
A new focus on small cell lung cancer
https://www.fredhutc[...]
2019-02-07
[79]
학술논문
Targeting NOTCH activation in small cell lung cancer through LSD1 inhibition
2019-02
[80]
웹사이트
Dustin Diamond, 'Saved by the Bell' Star, Dead at 44
https://www.etonline[...]
2021-02
[81]
학술논문
Asbjørn Sennels
https://www.ekstrabl[...]
2023-07-09
[82]
저널
Advanced small cell carcinoma of the uterine cervix treated by neoadjuvant chemotherapy with irinotecan and cisplatin followed by radical surgery
2011-03
[83]
저널
Pure small cell carcinoma of the prostate: a case report and literature review
2011-02
[84]
문서
small-cell carcinoma
[85]
웹인용
Small Cell Lung Cancer
https://rarediseases[...]
[86]
웹인용
Small cell carcinoma of the Lung and Bronchus
https://seer.cancer.[...]
U.S. National Cancer Institute
2016
[87]
저널
Chemotherapy advances in small-cell lung cancer
2013-10
[88]
저널
Staging and clinical prognostic factors for small-cell lung cancer
[89]
웹인용
Limited-stage small cell lung cancer: Initial management
https://www.uptodate[...]
UpToDate
2019-06-02
[90]
웹인용
Small Cell Lung Cancer Treatment
https://www.cancer.g[...]
National Cancer Institute, United States Department of Health and Human Services
2019-06-02
[91]
저널
Limited small-cell lung cancer: a potentially curable disease
https://www.cancerne[...]
2021-08-01
[92]
저널
Lambert-Eaton myasthenic syndrome: tumor versus nontumor forms
[93]
서적
Robbins and Cotran pathologic basis of disease
Elsevier Saunders
[94]
서적
Robbins Basic Pathology
Saunders
본 사이트는 AI가 위키백과와 뉴스 기사,정부 간행물,학술 논문등을 바탕으로 정보를 가공하여 제공하는 백과사전형 서비스입니다.
모든 문서는 AI에 의해 자동 생성되며, CC BY-SA 4.0 라이선스에 따라 이용할 수 있습니다.
하지만, 위키백과나 뉴스 기사 자체에 오류, 부정확한 정보, 또는 가짜 뉴스가 포함될 수 있으며, AI는 이러한 내용을 완벽하게 걸러내지 못할 수 있습니다.
따라서 제공되는 정보에 일부 오류나 편향이 있을 수 있으므로, 중요한 정보는 반드시 다른 출처를 통해 교차 검증하시기 바랍니다.
문의하기 : help@durumis.com
